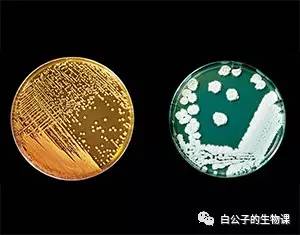
脚臭是因为真菌还是细菌,你的脚臭不臭

其实原因大家都说的很明白了,甚至具体到单个种类细菌,真的已经很清楚了。我还想说这个?怎么可能。

汗当然是没味的。脚汗和手汗没什么区别,哪里的汗腺都是汗腺。但是脚汗的特别在于脚部的细菌和真菌格外多。
科学研究已经发现,人体表面细菌和真菌最多的地方就是脚。原因其实很简单,因为只有脚是整天无法暴露在外的。所有暴露在外的地方都不会轻易有臭味。越捂越臭。

还可以再深挖一层。为什么不暴露就会臭?(比如男人的两股之间,女人的两股之间不怎么臭,除非阴道有炎症,炎症也就代表厌氧菌繁殖了)因为只有在不暴露的条件下,那些厌氧的细菌才会大量繁殖。也只有厌氧细菌才会发出大量的臭味。当然脚气脱皮是因为真菌。需氧细菌其实是无辜的。
其实我想说的现在才开始。杀菌就能治疗你的脚臭,脚气和脱皮?

我认为单纯地为了杀灭细菌真菌而使用的药物是不会有多大作用的。记得一句诗?野火烧不尽,春风吹又生。药物就是那野火,细菌真菌就是那青草。你永远无法杀尽。
事实上如果你杀尽了,你就会真的生更严重的病。

有人不懂了。为什么?细菌真菌不是坏的吗?杀死了应该健康啊?这是个非常错误的思想。是一个已经过时的思想。现在的科学已经不这样认为了。不要被舒肤佳广告所蒙蔽。
细菌真菌是你身上的共生体。注意,甚至不是寄生。它们在你身上与你一同生长,永远无法被彻底消灭,一辈子都会陪伴你,甚至在你死了以后还会伴随你直到你变成一堆白骨也不会彻底离开你。多么深沉的爱。
它们有用吗?有的。它们为你的免疫系统提供了一种温和的刺激,可以提高免疫系统的应答水平,换句话说如果你身上没有细菌你的免疫系统会彻底紊乱。除此之外它们甚至还可以调节你的情绪,你的内分泌,你的整个身体和心灵。你不是依靠它们。你和它们是共生的。
所以向那些使用达克宁的亲,我觉得这不是个好方法。事实上我也用过。被亲人传染了脚气……脚气经常在亲人之间传染。但是基本没用。如果其中有激素,激素只是调节了你的免疫系统,而不是仅仅杀菌。

如果你问我,脚臭脚气脱皮怎么解决?我比较赞同那位用醋的亲。因为我每天就是用醋和盐撒在水里洗脚的。现在我的脚气基本消失,脱皮只限制在最低水平。也不算臭。至少必须靠到鼻子上才能闻到淡淡(蛋蛋?)的臭味。
别说我没有统计学……您先试试。反正醋和盐真不贵。欢迎反馈。而且这对人体毫无副作用。您会觉得非常舒服的。

这也是在杀菌,但是是在温和地降低细菌的种群密度,也就是数量。降低了细菌和真菌的数量,臭味和脱皮都会消失。就像你几天不洗澡身上就臭了一样。每天都要洗澡哦。
这就是我要说的话。请不要虐待你身上的细菌和真菌。它们是你的盟友,共生一辈子的情人。请温和地对待它们。
